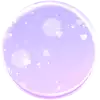
°아효♡°

시청자수 추이
애청자 수 추이
평균 시청자수
0
최대 시청자수
0
평균 애청자 수
0
최대 애청자 수
0
방송 기록
총 방송 수
17
평균 방송 시간
2시간 44분
총 방송 시간
46시간
최장 방송
5시간 44분
| 방송 제목 | 시간 | 피크 | 평균 | 카테고리 |
|---|---|---|---|---|
| 화장해봣심 ! 윅이짱!!4회 변경 | 6/1 21:37~00:46 (3h9m) | 16 | 7 | Talk/Cam |
| 점심 맛잇게 먹엉 !2회 변경 | 5/30 07:08~12:53 (5h44m) | 41 | 8 | Talk/Cam1회 변경 |
| 게임해볼게 같이할사람?1회 변경 | 5/19 11:56~17:38 (5h42m) | 10 | 10 | VALORANT |
| 수다 타임 | 5/18 22:40~23:19 (0h39m) | 13 | 11 | Talk/Cam |
| 쌩얼로 왓심♥ | 5/13 19:17~21:23 (2h6m) | 16 | 10 | Talk/Cam1회 변경 |
| 라디오♥2회 변경 | 4/30 14:50~18:56 (4h6m) | 8 | 4 | Dubbing/Radio1회 변경 |
| 라디오 수다 | 4/27 18:02~20:10 (2h7m) | 12 | 5 | Talk/Cam |
| 그냥 코스프레같은거 | 4/20 19:22~20:16 (0h54m) | 25 | 25 | Talk/Cam |
| 오늘은 머리 감고 수다 떨러 왔따 썬업!4회 변경 | 4/16 17:05~19:18 (2h12m) | 19 | 5 | Talk/Cam |
| 간만에 쌩얼인데 수다나 떨자1회 변경 | 4/12 18:13~20:26 (2h13m) | 20 | 7 | Talk/Cam |